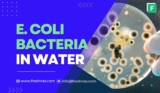
E Coli In Water (Everything You Need To Know)

Unbiased resources on how to test for and treat common city water and well water contaminants in your home so you have a safe water supply
Water Contaminants
If you're a well water user, you might have pondered the presence of sediment in your water supply. Questions pop up: What is this sediment, where does it ...
Mercury in water is similar to lead in that it is a bio accumulative toxin. This means that even small amounts of organic mercury can lead to negative health ...
Chloroform - a colorless liquid with a notorious past as an anesthetic - has found its way into an unexpected place: our drinking water. This revelation ...
Although E. coli and Fecal coliforms are typically harmless, a positive test can indicate that harmful germs are lurking in your water supply. This guide ...
Aluminum is a versatile metal used in countless applications, from constructing automotive engines to helping purify drinking water. But is water contaminated ...
Atrazine, a prevalent synthetic organic compound used as a herbicide, predominantly targets grassy weeds in agricultural areas, notably corn fields. Despite ...
Barium compounds, whether soluble or insoluble, find their way into our water systems through natural and human activities. Soluble compounds, such as barium ...
Haloacetic acids are a relatively new group of disinfection by-products contaminating our drinking water supplies. As the disinfection process used by ...
Glyphosate, the most widely used herbicide globally, is an integral part of agricultural operations. However, the contamination of municipal drinking water ...
Among the numerous contaminants raising alarms, benzene in water stands out as a particularly worrisome threat. This colorless, flammable liquid, is notorious ...
Copper is an essential nutrient for our bodies, however, consuming too much of it can lead to negative health consequences. Since copper in water is the most ...
Iron in water is a vexing issue for homeowners, especially those on well water. Doubts creep in as you pour a glass of water and glimpse its reddish hue. ...
The hormone estrogen, among other estrogen compounds, is frequently found in surface water, wastewater, and drinking water. Importantly, synthetic estrogen in ...
Although nitrate contamination is generally not a problem in public water systems since the Environmental Protection Agency (EPA) closely regulates the amount ...
Arsenic in drinking water is toxic even at low levels and is a known carcinogen. But we also know that Arsenic is one of the most common contaminants found ...
Hexavalent chromium, or chromium-6, has been recognized as a known carcinogen that can lead to adverse health effects if ingested in even trace amounts. If ...
Public water systems are frequently treated with chlorination to kill harmful microbial contaminants that are known to cause disease. However, this process ...
Most water supplies, both public and private, contain trace amounts of heavy metals, including aluminum, copper, lead, and arsenic. These minerals can be ...
Volatile organic compounds (VOCs) are a group of organic chemicals that can evaporate and turn into gases at normal air temperatures. Concerns about VOCs in ...
While chlorine is commonly used to disinfect water and eliminate harmful bacteria, an excessive amount can have adverse effects on human health. As water ...